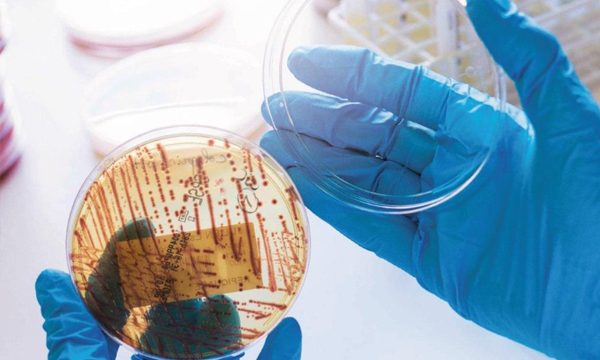
Science & Vie Antibiorésistance

« L’antibiorésistance a toujours un coup d’avance », à retrouver dans le Hors-série de Science & Vie n°316
Science & Vie est un magazine mensuel français de vulgarisation scientifique créé en 1913. Des sujets complexes aux questions pratiques de la vie quotidienne, en passant par les grands sujets de société, Science & Vie est le magazine scientifique grand public de référence, dont l’objectif est de cultiver la curiosité, l’émerveillement et l’intelligence de ses lecteurs.
Dans le dernier Hors-série n°316 (octobre 2024), un article est consacré à la résistance aux antimicrobiens. Intitulé « L’antibiorésistance a toujours un coup d’avance », il s’agit d’un entretien réalisé avec Marie-Cécile Ploy (Directrice de l’UMR 1092 RESINFIT, professeur de microbiologie et chef du service bactériologie-virologie-hygiène au CHU de Limoges) et Jean-Yves Madec (Directeur scientifique antibiorésistance de l’Anses). Dans cet article, ils reviennent sur ce fléau que représente l’antibiorésistance.
« L’antibiorésistance est responsable de 1,27 million de décès dans le monde chaque année – soit autant que la tuberculose et deux fois plus que le paludisme. C’est assez incroyable de se dire que l’on peut mourir, en 2024, de maladies infectieuses pour lesquelles des traitements devraient fonctionner ! », alerte notamment Marie-Cécile Ploy. Un extrait est disponible sur la plateforme en ligne Everand. Le Hors-série de Science & Vie est disponible à la lecture en ligne avec un abonnement.


